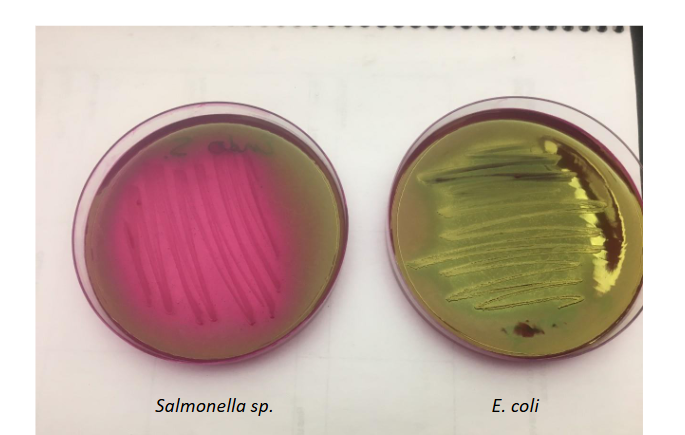

Plates & Virus
0.0(0)
Card Sorting
1/14
There's no tags or description
Looks like no tags are added yet.
Study Analytics
Name | Mastery | Learn | Test | Matching | Spaced |
|---|
No study sessions yet.
15 Terms
1
New cards

Absorption
2
New cards

Assembly
3
New cards

Bacterial Cell
4
New cards

Nucleic Acid Replication
5
New cards

Penetration
6
New cards

Protein Production
7
New cards

Release
8
New cards
Endo Plates after 48 hours incubation at 37C
9
New cards

Levine Plates after 48 hours incubation at 37C
10
New cards

MSA plate
Yellow media means bacteria ferments mannitol
11
New cards

MSA plate
Red media means no color change. Did not ferment mannitol
12
New cards

MAC
Lactose –
Fermentation = pink
colonies
13
New cards

MAC
No fermentation =
whitish-grayish colonies
14
New cards

Blood Agar Plate
Alpha hemolysis
15
New cards

Blood Agar Plate
Beta hemolysis